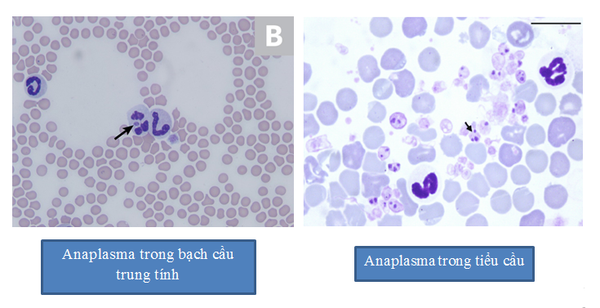
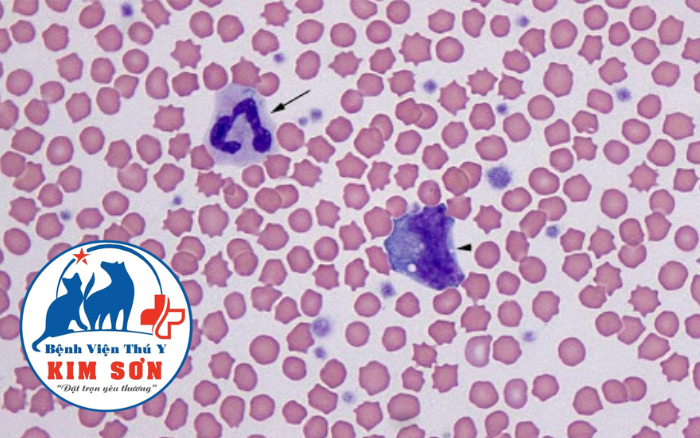
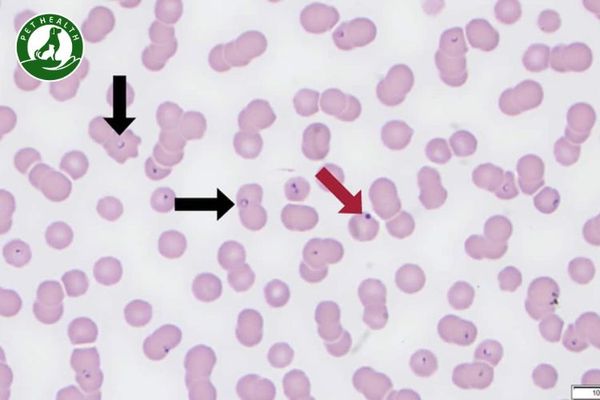
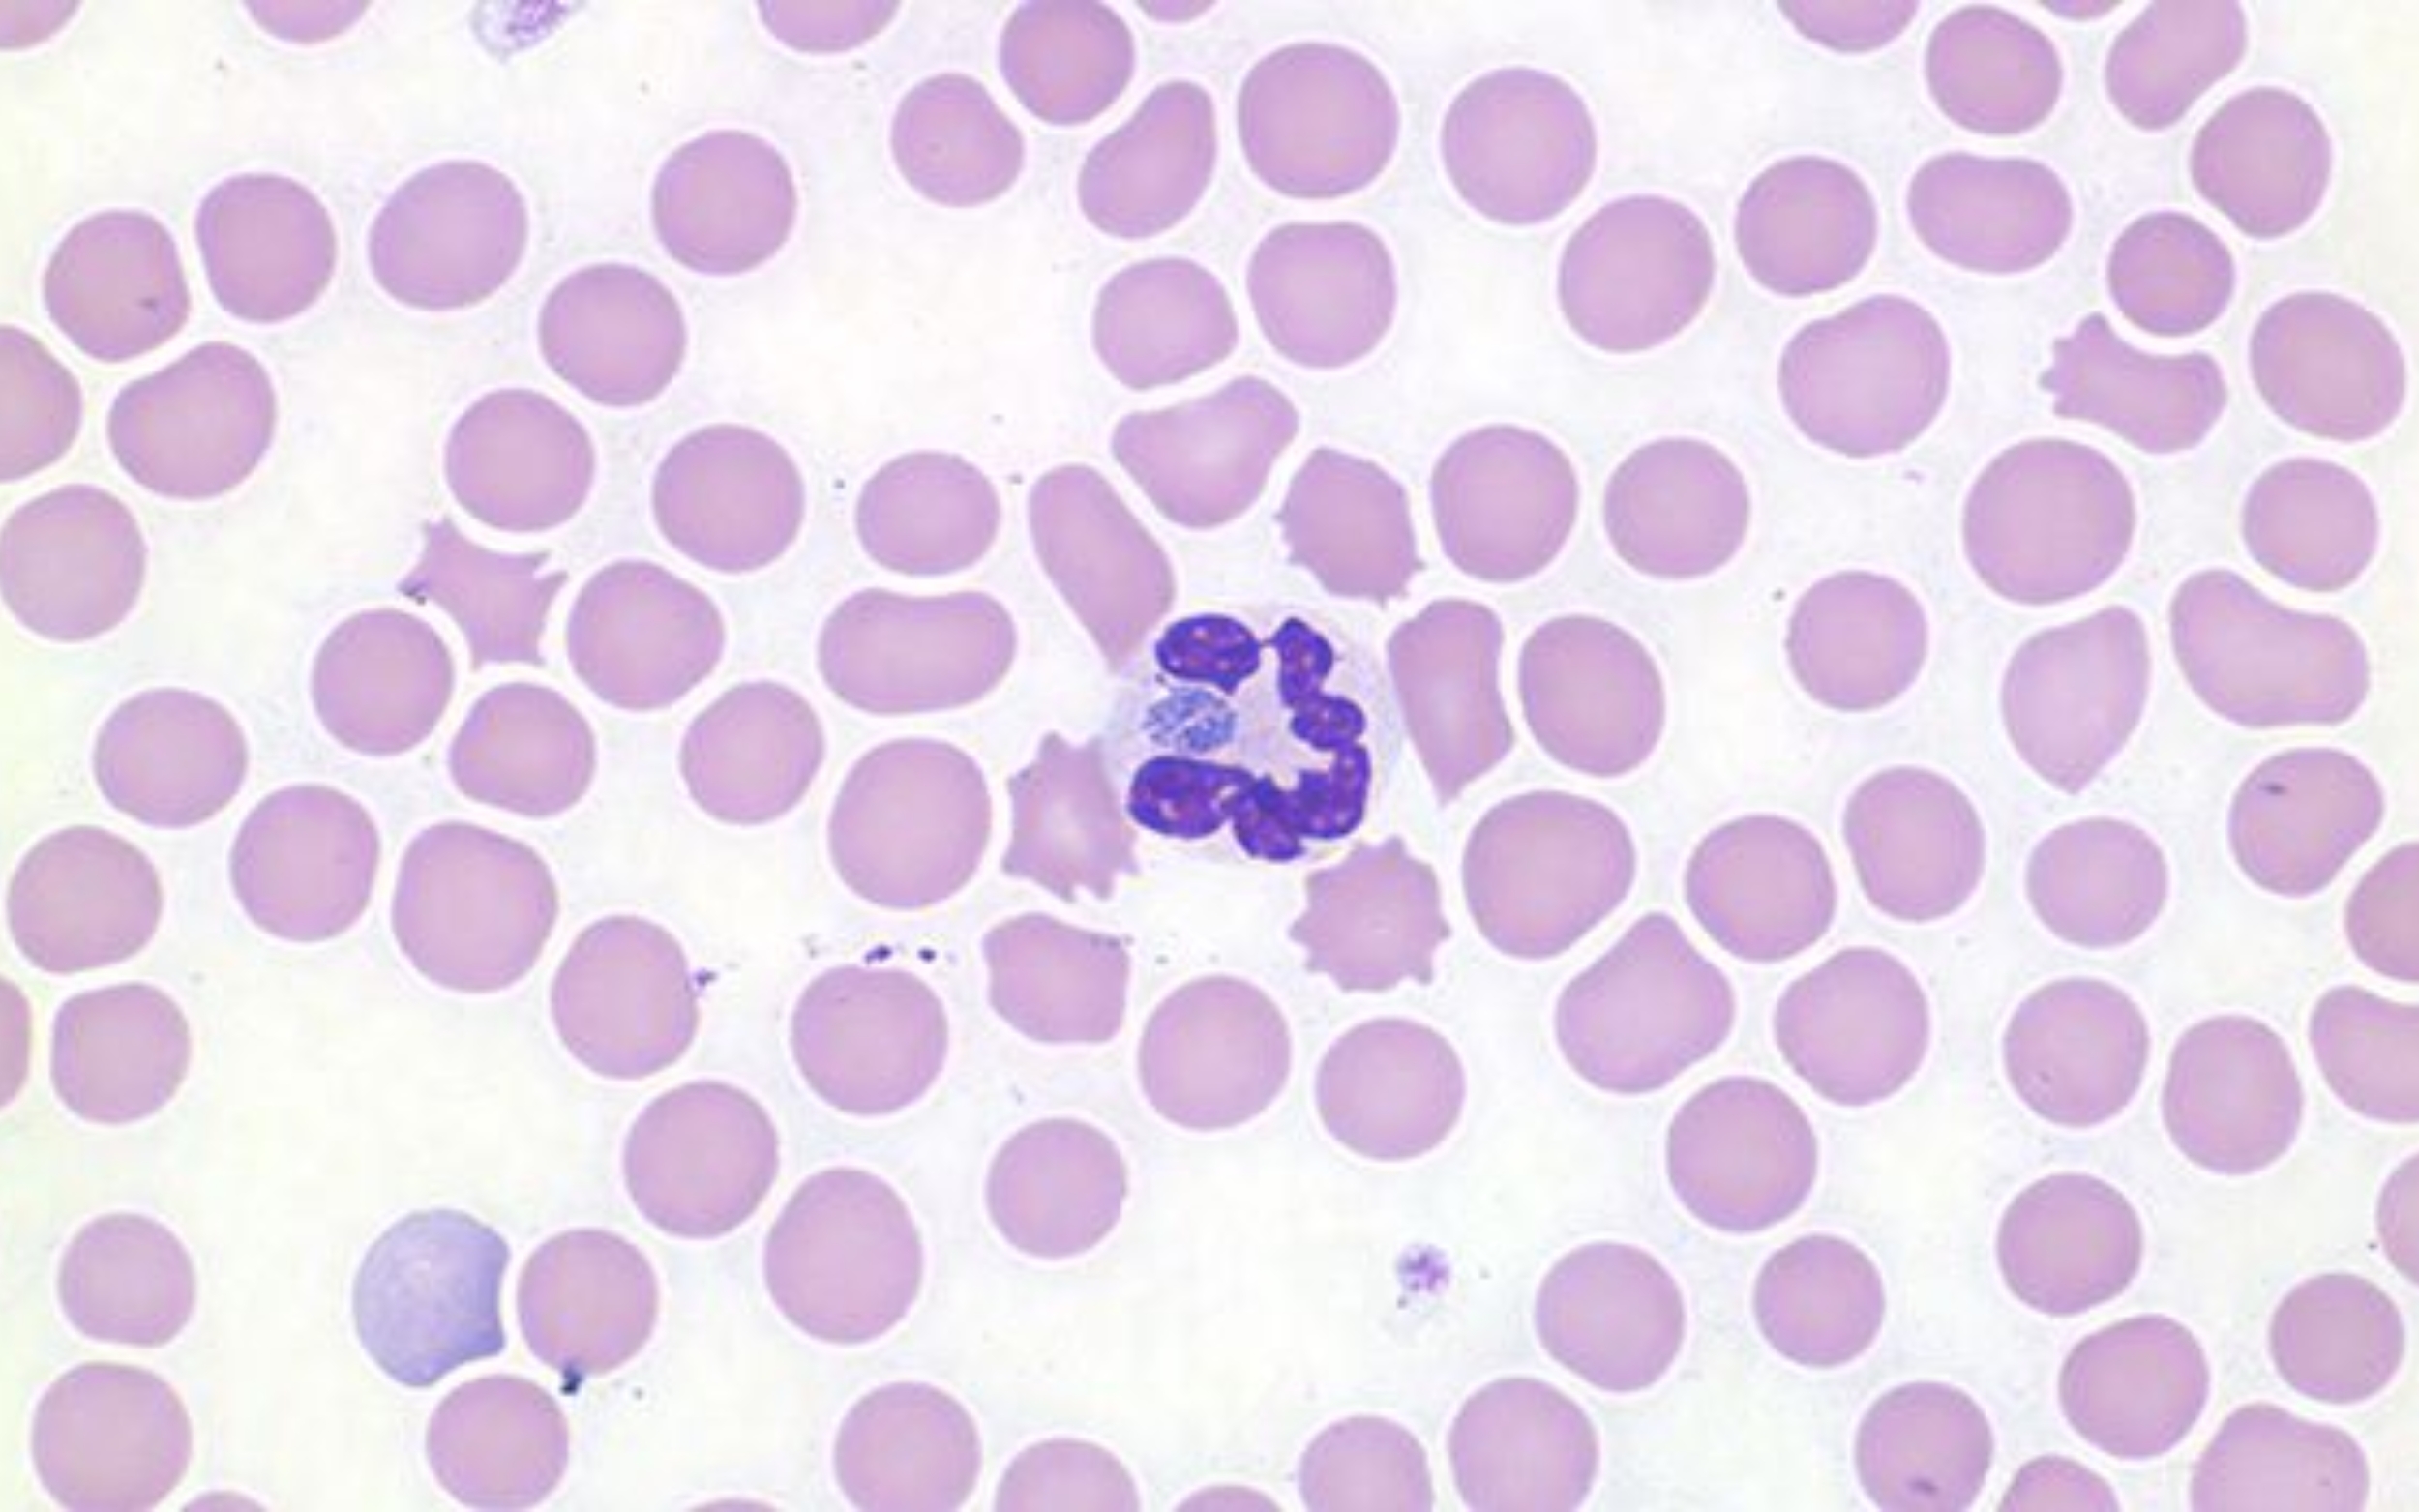

Physical Address
304 North Cardinal St.
Dorchester Center, MA 02124
Physical Address
304 North Cardinal St.
Dorchester Center, MA 02124

Bạn có nuôi mèo không? Nếu có, chắc hẳn bạn từng lo lắng khi “hoàng thượng” của mình bỗng nhiên mệt mỏi, bỏ ăn hay sốt cao mà không rõ nguyên do. Một trong những bệnh lý nguy hiểm có thể gặp ở mèo, và cũng khá phổ biến, chính là ký sinh trùng máu. Căn bệnh này nghe tên đã thấy đáng sợ, nhưng nếu nhận biết sớm và xử lý kịp thời thì lại hoàn toàn có thể kiểm soát được. Trong bài viết này, chúng ta sẽ cùng tìm hiểu tất tần tật về ký sinh trùng máu ở mèo – từ dấu hiệu nhận biết, nguyên nhân, tác hại, cách chữa trị, cho đến những lưu ý quan trọng để bảo vệ sức khỏe cho “boss” của mình nhé!
Ký sinh trùng máu ở mèo là một bệnh nhiễm trùng máu khá nguy hiểm, gây ra bởi các loại ký sinh trùng như Haemobartonella felis, Anaplasma và Cytauxzoon felis. Những con ký sinh này sống trong máu của mèo và tấn công vào các tế bào hồng cầu, gây ra những ảnh hưởng xấu đến sức khỏe của thú cưng.
Khi mèo bị nhiễm bệnh này, bạn sẽ nhận thấy những dấu hiệu khá rõ ràng. Mèo sẽ sốt cao, mệt mỏi, suy nhược và ít vận động. Ngoài ra, thú cưng của bạn có thể chán ăn, bỏ ăn đột ngột và sụt cân nhanh chóng.
Các biểu hiện khác cũng rất đáng chú ý, như nôn mửa, buồn nôn, tiêu chảy, mất nước và uống nhiều nước. Trong những trường hợp nặng, mèo có thể xuất huyết, vàng da, niêm mạc nhợt nhạt, thậm chí có máu trong phân hoặc nước tiểu. Nếu không được phát hiện và điều trị kịp thời, bệnh có thể dẫn đến tử vong.
Nếu bạn nuôi mèo, hãy chú ý đến những dấu hiệu cảnh báo của bệnh ký sinh trùng máu. Đây là tình trạng khá nguy hiểm nhưng hoàn toàn có thể phát hiện sớm nếu bạn quan sát kỹ thú cưng của mình.
Dấu hiệu đầu tiên thường là sốt cao kéo dài. Mèo sẽ trở nên mệt mỏi, ít vận động và không còn năng động như trước. Nếu thấy mèo chán ăn, bỏ ăn đột ngột hoặc sụt cân nhanh chóng, đó là tín hiệu cần cảnh báo.
Bạn cũng nên để ý đến những thay đổi về ngoại hình. Mèo có thể bị vàng da, niêm mạc nhợt nhạt do thiếu máu. Nếu thấy mèo nôn mửa, buồn nôn hoặc có rối loạn tiêu hóa như tiêu chảy, đó cũng là những dấu hiệu đáng lo ngại.
Trong những trường hợp nặng hơn, mèo có thể xuất huyết với máu lẫn trong phân, nước tiểu hoặc chảy máu từ mũi. Nếu phát hiện bất kỳ triệu chứng nào trong số này, hãy đưa mèo đến bác sĩ thú y ngay để được chẩn đoán và điều trị kịp thời.
Bệnh ký sinh trùng máu ở mèo là một vấn đề sức khỏe khá phổ biến mà các chủ nhân mèo cần chú ý. Nguyên nhân chính gây ra bệnh này là do các loại ký sinh trùng như Mycoplasma haemofelis, Anaplasma và Cytauxzoon felis xâm nhập vào máu của mèo.
Đường lây nhiễm chính là thông qua các côn trùng, đặc biệt là ve và bọ chét. Khi những côn trùng này cắn mèo, chúng sẽ truyền ký sinh trùng vào cơ thể thông qua vết thương. Đây là hình thức lây nhiễm phổ biến nhất mà bạn cần phòng tránh bằng cách vệ sinh môi trường sống của mèo.
Ngoài ra, ký sinh trùng máu cũng có thể lây truyền từ mẹ sang con trong quá trình mang thai hoặc qua sữa mẹ. Mèo cũng có thể bị nhiễm khi tiếp xúc trực tiếp với máu của mèo bị bệnh khác, hoặc khi sống trong môi trường nhiễm trùng.
Những mèo có hệ miễn dịch yếu sẽ có nguy cơ cao hơn bị mắc bệnh này. Vì vậy, việc chăm sóc sức khỏe tổng quát và phòng ngừa ký sinh trùng là rất quan trọng để bảo vệ thú cưng của bạn.

Ký sinh trùng máu là một trong những mối đe dọa lớn nhất đối với sức khỏe của mèo cưng. Những sinh vật nhỏ bé này sống trong máu và tấn công trực tiếp vào các tế bào hồng cầu, gây ra những hậu quả nghiêm trọng mà chúng ta không thể xem nhẹ.
Khi mèo bị nhiễm ký sinh trùng máu, cơ thể chúng sẽ trở nên suy nhược và mệt mỏi. Mèo sẽ chán ăn, bỏ ăn đột ngột và sụt cân nhanh chóng, khiến chúng ngày càng yếu ớt. Sốt cao là triệu chứng ban đầu thường gặp, kèm theo đó là các dấu hiệu rối loạn tiêu hóa như nôn mửa, tiêu chảy và buồn nôn.
Những ảnh hưởng sâu hơn là thiếu máu tán huyết, khiến niêm mạc của mèo trở nên nhợt nhạt, da vàng ửng. Trong các trường hợp nặng, mèo có thể xuất huyết, thậm chí có máu trong phân và nước tiểu. Nếu không được phát hiện và điều trị kịp thời, bệnh có thể dẫn đến tử vong.

Bạn có biết ký sinh trùng máu ở mèo thường lây qua ve, bọ chét hay ruồi cắn không? Để bảo vệ “boss” nhà mình, hãy bắt đầu bằng việc tẩy ve bọ chét định kỳ nhé. Dùng thuốc nhỏ gáy, xịt phòng ngừa hoặc sữa tắm chuyên dụng, làm đều đặn mỗi tháng để loại bỏ những “kẻ xấu” này ngay từ đầu.
Tiếp theo, giữ môi trường sống của mèo sạch sẽ là chìa khóa vàng. Lau chùi khử khuẩn chuồng trại, nhà cửa thường xuyên, giữ khô ráo để ve rận không có chỗ sinh sôi. Nếu nhà có nhiều mèo, cách ly ngay nếu phát hiện con nào có ve, tránh lây chéo.
Đừng quên hạn chế mèo tiếp xúc với mèo hoang hay mèo lạ, vì chúng dễ mang mầm bệnh qua vết thương hở. Kết hợp tiêm phòng đầy đủ và cho ăn dinh dưỡng giàu sắt như thịt bò, gan, cá hồi để tăng sức đề kháng.
Cuối cùng, khám định kỳ tại bác sĩ thú y giúp phát hiện sớm. Chỉ cần kiên trì những bước đơn giản này, mèo yêu của bạn sẽ khỏe mạnh, vui đùa bên bạn mãi mãi!
Nếu mèo nhà bạn có dấu hiệu mệt mỏi, bỏ ăn hay sốt cao, rất có thể bé đang bị ký sinh trùng máu – một bệnh nguy hiểm lây qua ve, bọ chét. Đừng hoảng, nhưng hãy đưa bé đến bác sĩ thú y ngay lập tức để xét nghiệm máu xác định loại ký sinh trùng cụ thể như Anaplasma hay Babesia.
Bác sĩ sẽ kê thuốc phù hợp, thường là kháng sinh như Doxycycline, Azithromycin hay Clindamycin, dùng đường uống hoặc tiêm để tiêu diệt ký sinh trùng nhanh chóng. Nếu bé thiếu máu nặng, có thể cần truyền máu hỗ trợ, kèm vitamin và dinh dưỡng để phục hồi sức.
Trong quá trình điều trị, bạn cần theo dõi sát sao, cho bé ăn thức ăn giàu sắt như gan, cá hồi, giữ vệ sinh chuồng trại sạch sẽ. Tái khám định kỳ để đảm bảo ký sinh trùng hết hẳn.
Để tránh tái phát, hãy tẩy ve bọ chét định kỳ bằng thuốc nhỏ gáy hoặc xịt, không để mèo ra ngoài tự do. Chăm sóc tốt thế này, bé sẽ khỏe mạnh trở lại nhanh thôi!

Nếu mèo nhà bạn bị ký sinh trùng máu, chi phí điều trị có thể dao động khá rộng, tùy thuộc vào mức độ bệnh và nơi khám chữa. Thường thì bắt đầu bằng xét nghiệm máu để chẩn đoán chính xác, như soi ký sinh trùng máu chỉ khoảng 300.000 đồng thôi, giúp phát hiện Haemobartonella felis hay Cytauxzoon felis sớm.
Tiếp theo là thuốc đặc trị như kháng sinh, thuốc chống ký sinh trùng, dùng vài tuần đến vài tháng. Trường hợp nhẹ, tổng chi phí có thể từ 1-3 triệu đồng, bao gồm thuốc uống và theo dõi tại nhà. Còn nếu mèo thiếu máu nặng, cần truyền dịch, truyền vitamin (50.000-200.000 đồng/lần) hoặc thậm chí truyền máu, thì hóa đơn dễ đội lên vài chục triệu.
Điều trị nội trú ở bệnh viện thú y cũng tốn kém, khoảng 150.000-500.000 đồng/lần cho các bệnh nội khoa. Mình khuyên nên chọn phòng khám uy tín ở thành phố lớn, dù giá cao hơn nhưng thiết bị tốt, bác sĩ kinh nghiệm, giúp mèo hồi phục nhanh. Phòng ngừa bằng thuốc ve rận định kỳ sẽ tiết kiệm hơn nhiều đấy!

Nếu mèo nhà bạn bị nhiễm ký sinh trùng máu, thời gian khỏi bệnh không cố định mà phụ thuộc nhiều vào loại ký sinh trùng, mức độ nhiễm và tốc độ điều trị. Thường thì với thuốc đặc trị từ bác sĩ thú y, mèo có thể hồi phục sau 1-2 tuần nếu phát hiện sớm, nhưng nếu chậm trễ, bệnh có thể nguy kịch chỉ trong vài ngày.
Ký sinh trùng máu như Cytauxzoon felis hay các loại protozoa tấn công hồng cầu nhanh chóng, gây sốt, nướu nhợt, vàng da, mất nước và thậm chí hôn mê. Nhiều trường hợp không chữa kịp, mèo có nguy cơ tử vong trong 2 tuần đầu. Đó là lý do bạn cần đưa bé đến khám ngay khi thấy dấu hiệu lạ, làm xét nghiệm máu để xác định chính xác.
Quy trình điều trị thường dùng thuốc antiparasitic, antiprotozoal kết hợp kháng sinh, đôi khi phải nội trú theo dõi. Liều lượng tùy tình trạng, bác sĩ sẽ kê cụ thể. Sau đó, tái khám định kỳ để chắc chắn ký sinh trùng đã sạch hoàn toàn.
Để mèo mau khỏe, hãy bổ sung dinh dưỡng tốt, giữ vệ sinh và phòng ve định kỳ. Đừng tự mua thuốc, vì sai liều có thể hại bé thêm. Chăm sớm là cứu được mạng nhỏ của chúng đấy!

Bạn có biết ký sinh trùng máu ở mèo như Mycoplasma haemofelis hay Cytauxzoon felis gây thiếu máu nghiêm trọng cho boss nhà mình không? Chúng thường lây qua ve, bọ chét cắn hoặc tiếp xúc máu mèo bệnh, thậm chí mẹ truyền sang con.
May mắn thay, hầu hết các loại ký sinh trùng máu ở mèo không lây sang người. Chúng chuyên tấn công mèo, không dễ dàng nhảy sang chúng ta nhờ sự khác biệt hệ miễn dịch.
Tuy nhiên, một số trường hợp hiếm như Bartonella henselae (gây bệnh mèo cào) có thể truyền qua vết cào, cắn hoặc bọ chét, dẫn đến sốt, sưng hạch ở người. Haemoplasma hay Anaplasma cũng được ghi nhận lây qua ve từ mèo sang người, gây mệt mỏi, sốt cao nếu không điều trị.
Để an toàn, hãy tẩy ve bọ chét định kỳ cho mèo, tránh để chúng tiếp xúc máu bệnh và rửa tay sạch sau khi chơi. Như vậy, bạn vẫn ôm ấp boss mà không lo lắng nhé!
Việc đưa mèo đi khám bác sĩ thú y định kỳ là một phần quan trọng trong việc chăm sóc sức khỏe của thú cưng. Mèo con cần được khám khi được 6 tuần tuổi, sau đó mỗi 3-4 tuần một lần. Khi mèo trên bốn tháng tuổi, bạn nên đưa chúng khám hàng năm, còn mèo già cần khám sáu tháng một lần.
Ngoài lịch khám định kỳ, bạn cần chú ý đến những dấu hiệu cảnh báo. Nếu mèo biếng ăn, khó thở, nôn ói hoặc đi lại khó khăn, hãy đưa chúng đến phòng khám ngay. Những triệu chứng như tiêu chảy, rụng lông quá nhiều hay thay đổi hành vi cũng đòi hỏi sự chú ý của bác sĩ.
Khám định kỳ giúp phát hiện sớm các bệnh nguy hiểm như tim mạch, tiểu đường hay suy tuyến giáp mà ở giai đoạn đầu thường không có biểu hiện rõ ràng. Nếu bạn tự điều trị tại nhà mà tình trạng không thuyên giảm hoặc kéo dài lâu, cũng nên đưa mèo đi khám. Hãy chọn một phòng khám uy tín để đảm bảo mèo nhận được chăm sóc tốt nhất.

Ký sinh trùng máu ở mèo tuy là căn bệnh nguy hiểm nhưng hoàn toàn có thể phòng ngừa và kiểm soát nếu chúng ta hiểu biết và quan tâm đúng mức tới sức khỏe của thú cưng. Việc đưa mèo đi kiểm tra sức khỏe định kỳ, giữ vệ sinh môi trường sống, chú ý loại bỏ các tác nhân gây bệnh như ve, bọ là những bước rất quan trọng để bảo vệ các bé mèo khỏi căn bệnh này. Hãy dành thời gian quan sát và yêu thương mèo mỗi ngày, bởi đôi khi chỉ một thay đổi nhỏ cũng có thể cứu sống bạn đồng hành nhỏ bé của bạn.